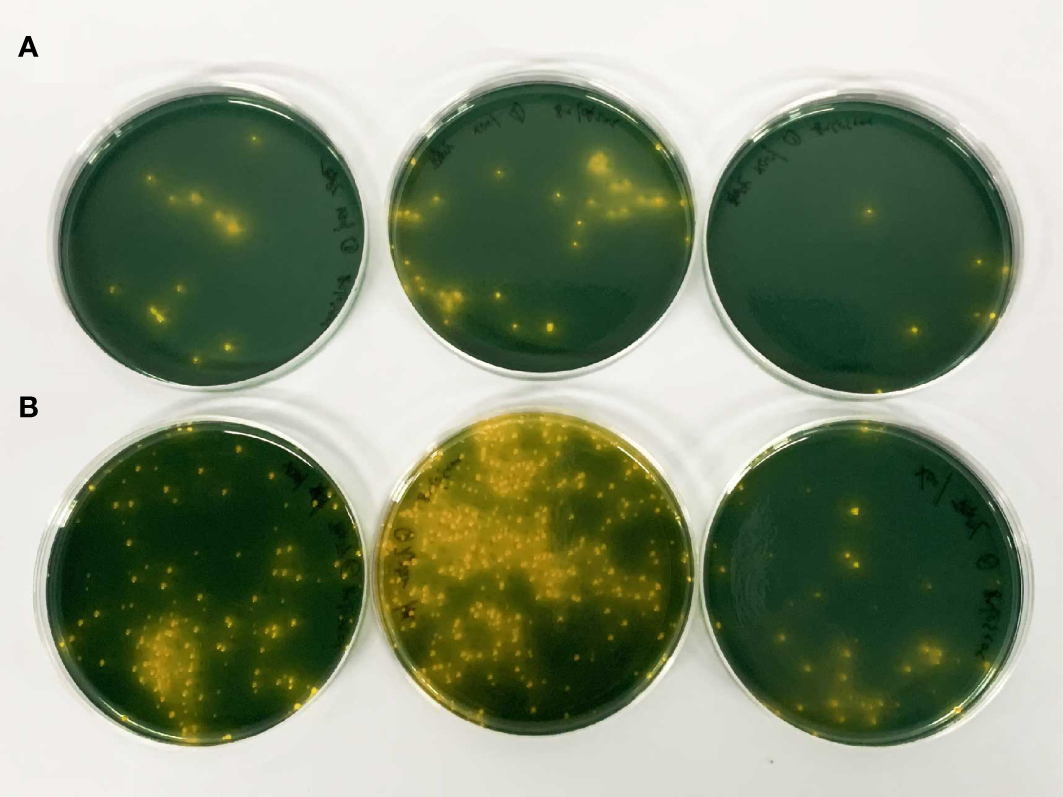
Figure 2

Abstract
Groupers, as a popular economic fish species, are now more frequently cultured in land-based facilities, however, traditional pond-farming methods are plagued by frequent disease outbreaks, unstable economic benefits, and environmental pollution. To explore a new farming mode for a grouper, an 80-day cultivation experiment was conducted using both a simulated pond system (SPS) and a recirculating aquaculture system (RAS). The research aims to evaluate the growth performance, health (pathogenic bacteria, intestinal microbiota), off-flavor compounds (geosmin, 2-methylisoborneol), and nutritional component (amino acids, fatty acid composition and content) of a hybrid grouper (Pinephelus fuscoguttatus ♀ × Epinephelus lanceolatus ♂) under different aquaculture systems. The results showed that the hybrid grouper in a RAS exhibited better growth performance; the concentration of Vibrio in the fish tissue in the RAS was significantly lower than that in the SPS. Moreover, the content of fresh amino acids in the RAS was significantly higher, and the levels of saturated fatty acids (SFAs) and ω-6 polyunsaturated fatty acids (ω-6PUFAs) were significantly higher in the RAS. This finding indicates the superior flavor and nutritional value of the grouper. These results prove that the RAS is suitable for the widespread cultivation of grouper.
1 Introduction
The rapidly growing world population has led to a rising demand for food, with seafood serving as an important source of protein for human consumption. In recent years, the decline in marine fisheries has driven the escalating interest in aquaculture. It is anticipated that aquaculture production will exceed 100 million tons by 2027 (FAO, 2022). The grouper, a tropical fish prized for its high nutritional and economic value, has become a popular species in both the Asian culinary and aquaculture industries. Hybrid grouper (Epinephelus fuscoguttatus ♀ × ♂ Epinephelus lanceolatus) shows superior growth performance and enhanced disease resistance compared to the parental strains, which has made it a popular choice in grouper aquaculture (Bunlipatanon and U-taynapun, 2017). Currently, the majority of grouper production comes from Asia, with China, Taiwan, and Indonesia, contributing to 92% of the global production (Rimmer and Glamuzina, 2019). Common forms of grouper farming include nearshore cage culture and pond culture (Rimmer and Glamuzina, 2019). Traditional modes of aquaculture have numerous drawbacks, including relatively outdated technology, frequent disease outbreaks, and wastage of water resources. Most importantly, the discharge of large quantities of nitrogen, phosphorus, solid waste, and chemical residues from traditional open aquaculture can lead to water pollution, adversely influencing the aquatic ecosystem at greater depths (Yue and Shen, 2022; Cherian et al., 2023). These problems have attracted widespread attention from various sectors of society. Additionally, climate change and extreme weather events have caused significant economic losses for traditional aquaculture (Muhala et al., 2021). This trend has prompted the search for more sustainable ways to meet the demand for seafood, with new aquaculture technologies being crucial in addressing the current challenges.
In recent years, the recirculating aquaculture system (RAS) has emerged as a hot topic in the aquaculture industry due to its high productivity and eco-friendly performance. The industrial-scale RAS is an environmentally friendly, water-saving, and land-saving intensive farming model. In a RAS, harmful substances such as high-concentration ammonia nitrogen and nitrite produced in the aquaculture ponds were treated through mechanical filtration, biological purification, and sterilization before being returned to the aquaculture ponds, forming a closed-loop system (Li et al., 2023b). This system was unaffected by external environmental conditions and enabled precise control of aquaculture conditions. Additionally, its extremely low water exchange volume meant minimal wastewater discharge, contributing to water resource conservation. Therefore, an industrial-scale RAS was considered to be a highly promising, environmentally friendly, aquaculture mode (Li et al., 2023a).
Factors such as the location, water quality, and farming conditions of different aquaculture modes can affect the growth metabolism, intestinal status, and nutritional composition of farmed organisms (Zhang et al., 2020). Hu et al. (2021) compared the nutritional quality differences of bighead carp in regular farming ponds, natural lakes, and reservoirs, and discovered that the bighead carp from the reservoirs contained a wider variety of unsaturated fatty acids and higher levels of total polyunsaturated fatty acids, while those from farming ponds contained more off-flavor substances. Ma et al. (2023) compared the differences in the quality of carp in ponds and RASs, revealing significant influences of the farming mode on the physical properties, nutritional components, mineral elements, volatile substances, and serum biochemistry of the carp. Pond aquaculture is a widely used traditional land-based aquaculture model, accounting for 15.75% of China’s marine aquaculture production, while industrialized aquaculture (including RASs) only accounts for 2.1% (Edwards et al., 1997; Fisheries Bureau of the Ministry of Agriculture and Rural Affairs, 2023). As a modern and emerging system of land-based aquaculture, there have been reports of the use of RASs for grouper farming; however, there is limited comparative research available into the health and nutritional value of grouper under pond and land-based recirculating water farming systems. This study aims to compare the growth performance, safety, and nutritional value of groupers under two different farming conditions, offering valuable insights into the sustainable development of grouper aquaculture.
2 Materials and methods
2.1 Experimental material
The experimental fish could be procured from the same batch of grouper from Shandong Rizhao Hongqi Aquatic Products Co., Ltd. The SPS used PVC water tanks, with a depth of 700 mm, a bottom composed of silt, and a volume of 500 L and operated as a static water environment, with a daily water exchange rate of 50%. The RAS consisted of fish tanks, a microfilter, biofilters (fixed bed bioreactor), and ultraviolet sterilization tanks. The fish tank had a volume of 1200 L and a water flow rate of 200 L/h, with a daily water exchange rate of 5% (Figure 1). Each system comprised three parallel fish tanks. Lively and active groupers were selected and reared for 80 days using the simulated pond and RAS. The initial weight of the grouper was 115.58 ± 18.51 g. The initial stocking density was 30 fish/m3 in both systems. Both systems were maintained within the same indoor environment and utilized the same water source. During the experimental procedure, the temperature was maintained at 25.63 ± 0.38°C, dissolved oxygen (DO) levels were 6.68 ± 0.18 mg/L, salinity was 32.05 ± 1.28 ppt, and pH was 7.91 ± 0.10. The concentration of NH4+-N in the RAS during the experimental period was 0.38 ± 0.02 mg/L, and the concentration of NO2–N was 0.51 ± 0.001 mg/L. In the SPS, the concentration of NH4+-N ranged from 0.86 ± 0.30 mg/L to 1.26 ± 0.21 mg/L, while the concentration of NO2–N ranged from 1.02 ± 0.31 mg/L to 1.60 ± 0.17 mg/L.
Figure 1

Two aquaculture systems, (A) SPS; (B) the RAS.
2.2 Daily management
During the experiment, the fish were fed at 9:00 and 17:00, with a daily total feeding amount of 1.5% of the grouper’s body weight, manual feeding is adopted The grouper feed from Shandong Shengsuo Technology Co., Ltd was used, with the main composition being 48% crude protein, 9% crude fat, 17% crude ash, and 6% crude fiber. The ponds were inspected three times daily to observe any abnormalities in the grouper, and in the event of discovering dead fish, they were promptly removed and recorded.
2.3 Experimental method
2.3.1 Growth parameter
After the experiment, the individual weight and total weight of the grouper in both the SPS and RAS were measured to calculate the growth parameters of the grouper.
In the formulae: N0 represents the initial number of fish; Nd is the number of fish deaths; mt and m0 denote the final and initial fish body masses, g; t denotes the duration of the experiment, d; G represents the total feed amount, g.
2.3.2 Common pathogen examination
Three fish were randomly selected from each fish tank in both breeding systems, and 0.1 g of intestinal contents from each fish were ground. The resulting samples were then diluted 100-fold with sterile phosphate buffer saline (PBS) and evenly spread onto thiosulfate citrate bile-salt sucrose (TCBS) agar plates, followed by incubation at 37°C for 24 hours for Vibrio quantification (Mougin et al., 2021).
Bacterial genomic DNA was extracted using a commercial kit, and the 16S rDNA segment was amplified using PCR. After sequencing, the obtained sequences were compared against the NCBI database. Sequences with a similarity of over 99% could be considered to belong to the same bacterial species. Additionally, a small section of the grouper intestinal tract was fixed in 95% alcohol, and the genomic DNA was extracted for PCR amplification. Agarose gel electrophoresis was then adopted to ascertain whether the PCR products contained typical pathogens.
2.3.3 Analysis of intestinal flora
2.3.3.1 Structure and diversity of intestinal flora
The intestinal DNA samples were extracted using a commercial kit, and the extracted genomic DNA was checked by 1% agarose gel electrophoresis. Specific regions were amplified by using PCR with primers containing barcode tags. The PCR products from the same sample were pooled and checked via 2% agarose gel electrophoresis. The PCR products were then purified by the AxyPrep DNA Gel Extraction Kit (AXYGEN) and eluted with Tris_HCl. After purification, the DNA was quantified using the QuantiFluorTM-ST blue fluorescence quantification system (Promega). Subsequently, Illumina MiSeq 2 × 300 bp high-throughput sequencing and bioinformatics analysis were performed. Using QIIME Version 1.8.0 software, alpha diversity analysis of operational taxonomic units (OTUs) was conducted, encompassing Ace, Chao, and Shannon indices.
2.3.4 Analysis of off-flavor compounds
The gill, skin, intestinal, and muscle samples were extracted using acetonitrile. After adsorbing lipids, polymers, pigments, and other impurities using C18 and PSA, the samples were analyzed using a 6890N GS-5975 MS gas chromatography-mass spectrometer. The analysis utilized a DB-624UI capillary column (30 m × 0.25 mm × 1.40 μm). The temperature ramping program consisted of an initial temperature of 60°C, held for 2.5 minutes, followed by an increase at a rate of 15°C/min to 150°C, where it was maintained for five minutes, and then increased to 250°C at a rate of 5°C/min. The ion source was an electron impact ionization (EI) source at an ionization energy of 70 eV and a source temperature of 280°C. The scanning mode employed was selected ion monitoring (SIM) (Wang et al., 2023).
2.3.5 Analysis of muscle nutrients
Three fish were randomly selected from each fish tank in both the SPS and RAS systems, and their muscle tissues were subjected to measurements following the industrial standards below. The water content: the direct drying method, GB5009.3–2016. The ash content: the dry ashing method, GB5009.4–2016. The crude protein content: the Kjeldahl method, GB500. 5–2016. Crude lipid: The Soxhlet extraction method, GB5009. 6–2016 (Jia et al., 2022).
According to the industry standard (GB 5009.124–2016), the fatty acid composition was determined using a 7890 B gas chromatograph, and the relative percentage content of each major fatty acid was calculated using the area normalization method. Additionally, the amino acid composition of the muscle tissue of the grouper was determined using an A300 amino acid analyzer as per industry standard (GB 5009.124–2016), and the relative percentage content of each major amino acid was calculated using the area normalization method (Jia et al., 2022).
The nutritional value evaluation method: amino acid scores (AAS), chemical scores (CS), and the essential amino acid index (EAAI) were calculated based on the amino acid scoring pattern suggested by the Food and Agriculture Organization/World Health Organization, and the amino acid pattern of whole egg protein, using the following formulae (FAO/WHO,1973):
EA, EB, …, EH represent the content of those essential amino acids (EAAs) compared, EEA, EEB, …, EEH denote the content of EAAs in whole egg proteins, n is the number of EAAs compared.
2.4 Data processing
The data were analyzed using two-sample t-test in SSPS software. A difference with P < 0.05 was considered statistically significant, while that at P < 0.01 was deemed highly significant. The experimental data were presented as mean ± standard deviation.
3 Results
3.1 Growth performance
The growth parameters of the grouper in the two systems are listed in Table 1. In both aquaculture systems, the survival rate of the grouper was 100%. In the SPS, the individual weight of the grouper increased from 121.15 ± 17.32 g to 208.57 ± 37.38 g, resulting in a weight gain rate (WGR) of 72.16%. The SGR was 0.73, and the feed conversion ratio (FCR) was 1.21. In the RAS, the individual weight of the grouper increased from 115.58 ± 18.51 g to 233.81 ± 29.97 g, resulting in a WGR of 102.36%. The SGR was 0.87, and the FCR was 0.88. The SGR and FCR in the RAS were significantly higher than those in the SPS (P < 0.05). The performance of the grouper in the RAS was superior to that in the pond aquaculture system.
Table 1
| Index | SPS | RAS |
|---|---|---|
| Initial individual mass (g) | 121.15 ± 17.32 | 115.58 ± 18.51 |
| Final individual mass (g) | 208.57 ± 37.38 | 233.81 ± 29.97 |
| WGR (%) | 72.16 | 102.36 |
| SGR(%/d) | 0.73* | 0.87 |
| FCR | 1.21* | 0.88 |
Growth indicators of the grouper in two aquaculture models.
*Indicates a significant difference (P < 0.05).
3.2 Analysis of pathogenic bacteria and intestinal microorganisms
3.2.1 Comparison of pathogenic bacteria in two culture modes
Both aquaculture systems were found to have predominantly harbored Vibrio harveyi. The average count of Vibrio harveyi in the fish intestines within the RAS was 2.1 × 104 CFU/g, while in the pond simulation, the average count was 8.21 × 104 CFU/g. The pond count was significantly higher than that in the RAS (Figure 2).
Figure 2
Comparison of vibrio in the grouper (Pinephelus fuscoguttatus ♀× Epinephelus lanceolatus ♂) in two culture modes. (A) The RAS; (B) SPS.
In both the SPS and the RAS, Singapore grouper iridovirus (SGIV), acute hepatopancreatic necrosis disease (AHPND), and Enterocytozoon hepatopenaei (EHP) were not detected.
3.2.2 Comparison of intestinal microbes in two culture modes
The composition of intestinal microbiota in both aquaculture systems is shown in Figure 3. At the phylum level, the predominant microbial communities in both aquaculture systems were Firmicutes (45.76–58.51%), Proteobacteria (13.93–23.31%), Actinobacteriota (10.92–16.75%), Bacteroidota (4.58–6.53%), Desulfobacterota (1.62–3.86%), Chloroflexi (1.30–2.43%), Gemmatimonadota (0.86–1.53%), and Spirochaetota (1.07–1.31%). Significantly different relative abundances were observed in Proteobacteria, Bacteroidota, and Desulfobacterota (P < 0.05), while Actinobacteriota exhibited highly significant differences (P < 0.01).
Figure 3

Composition and abundance of intestinal microorganisms on phylum level in two different cultured grouper species (*, significant differences, P < 0.05,** indicates a highly significant difference (P < 0.01).
Microbial diversity analysis (Figure 4) indicated that there were no significant differences in the Ace index, Chao index, and Shannon index in the intestinal microbiota of the grouper between the two aquaculture systems.
Figure 4

Intestinal microbial diversity index in two different aquaculture modes.
3.3 Off-flavor compounds
In samples of gills, skin, liver, and muscle from both aquaculture modes, geosmin and 2-methylisoborneol were not detected. Off-flavor compounds in both aquaculture modes did not reach the limit of detection.
3.4 Nutrient analysis
3.4.1 Conventional nutrients
The conventional nutritional composition of the grouper in the two farming systems is displayed in Table 2. The muscle moisture, ash, crude protein, and crude lipid content of the grouper in both farming systems were found to be similar, with no significant differences (P > 0.05).
Table 2
| Items | SPS | RAS |
|---|---|---|
| Moisture | 75.14 ± 0.22 | 75.57 ± 0.12 |
| Ash | 1.32 ± 0.01 | 1.33 ± 0.003 |
| Crude protein | 20.93 ± 0.12 | 21.3 ± 0.16 |
| Crude lipid | 2.54 ± 0.08 | 2.62 ± 0.06 |
Essential nutrients in muscle of the grouper in two systems (%, n = 3, fresh sample).
3.4.2 Amino acids
The muscle amino acid content of the grouper in two aquaculture systems is displayed in Table 3. A total of 18 amino acids and taurine were detected, including eight EAAs, six non-essential amino acids (NEAAs), and four delicious amino acids (DAAs). The levels of threonine, lysine, histidine, and proline in the RAS were significantly higher than those in the SPS. Meanwhile, the levels of serine, isoleucine, and tyrosine in the SPS were significantly higher than those in the RAS. There were no significant differences in the total amounts of EAAs and NEAAs between the two systems. The DAA content in the RAS was significantly higher than that in SPS, indicating that the culture system significantly affects the muscle flavor of the grouper.
Table 3
| Amino acids | SPS | RAS |
|---|---|---|
| Taurine | 0.93 ± 0.06 | 0.96 ± 0.06 |
| Aspartic acid | 7.88 ± 0.01 | 7.80 ± 0.02 |
| Threonine | 3.26 ± 0.02* | 3.44 ± 0.02 |
| Serine | 3.48 ± 0.05* | 3.06 ± 0.07 |
| Glutamic acid | 11.92 ± 0.32 | 11.69 ± 0.49 |
| Glycine | 3.43 ± 0.03* | 4.15 ± 0.13 |
| Alanine | 4.45 ± 0.19 | 4.49 ± 0.28 |
| Cysteine | 1.78 ± 0.11 | 1.78 ± 0.15 |
| Valine | 2.77 ± 0.02* | 2.60 ± 0.07 |
| Methionine | 2.29 ± 0.02 | 1.98 ± 0.10 |
| Isoleucine | 2.61 ± 0.32 | 2.56 ± 0.04 |
| Leucine | 5.70 ± 0.14 | 5.52 ± 0.19 |
| Tyrosine | 2.56 ± 0.06* | 2.27 ± 0.01 |
| Phenylalanine | 3.03 ± 0.08 | 2.96 ± 0.11 |
| Lysine | 6.87 ± 0.14 | 6.69 ± 0.27 |
| Histidine | 1.43 ± 0.02* | 1.82 ± 0.06 |
| Arginine | 4.27 ± 0.08 | 4.16 ± 0.13 |
| Proline | 2.33 ± 0.07* | 2.41 ± 0.13 |
| Tryptophan | 3.57 ± 0.3 | 4.05 ± 0.72 |
| EAA | 26.00 ± 0.27 | 26.63 ± 0.21 |
| NEAA | 20.60 ± 0.20* | 21.85 ± 0.25 |
| DAA | 27.31 ± 0.26* | 28.66 ± 0.03 |
| TAA | 70.47 ± 0.52 | 71.32 ± 0.88 |
The composition acid in muscle of the grouper in two systems (%, n = 3, dry matter).
*indicates a significant difference (P < 0.05). EAA refers to the total content of essential amino acids; NEAA refers to the total content of non-essential amino acids; DAA represents the total content of delicious amino acids, and TAA refers to the total amino acid content.
Table 4 shows that the EAA content in both aquaculture systems was close to the FAO/WHO pattern but lower than that of whole egg protein model. In the AAS scoring results, both lysine and methionine-cysteine scores were higher than 1. In both the SPS and RAS, the first and second limiting amino acids were valine and isoleucine.
Table 4
| Essential amino acid | AAS | CS | ||
|---|---|---|---|---|
| SPS | RAS | SPS | RAS | |
| Threonine | 0.82 | 0.83 | 0.70 | 0.72 |
| Valine | 0.56 | 0.52 | 0.42 | 0.41 |
| Isoleucine | 0.64 | 0.65 | 0.48 | 0.46 |
| Leucine | 0.81 | 0.78 | 0.67 | 0.65 |
| Lysine | 1.25 | 1.23 | 0.96 | 0.95 |
| Methionine-cysteine | 1.12 | 1.13 | 0.64 | 0.65 |
| Tyrosine-phenylalanine | 0.91 | 0.87 | 0.61 | 0.59 |
| EAAI | – | – | 62.06 | 61.2 |
Comparison of AAS, CS, and EAAI between two systems cultured grouper (%, n = 3, fresh sample).
3.4.3 Fatty acids
According to Table 5, a total of 17 fatty acids were detected, including four saturated fatty acids (SFAs), four monounsaturated fatty acids (MUFAs), and nine polyunsaturated fatty acids (PUFAs). The most abundant fatty acid in the grouper from both aquaculture systems was C18:2n-6. The levels of C17:1n-7, C20:3n-3, and ω-3PUFA in the muscle of grouper from the SPS were significantly higher than those in the RAS (P < 0.05). Conversely, the relative contents of C14:0, SFA, C18:2n-6, C20:2n-6, and ω-6PUFA in the muscle of grouper from the RAS were significantly higher than those in the SPS (P < 0.05), enhancing the maintenance of human health and nutritional balance.
Table 5
| Fatty acid | SPS | RAS |
|---|---|---|
| C14:0 | 3.22 ± 0.14* | 3.50 ± 0.49 |
| C16:0 | 19.55 ± 0.13 | 19.47 ± 0.03 |
| C18:0 | 4.98 ± 0.12 | 4.78 ± 0.08 |
| C20:0 | 0.27 ± 0.01 | 0.29 ± 0.01 |
| ΣSFA | 27.94 ± 0.04* | 28.38 ± 0.03 |
| C14:1n-5 | 0.27 ± 0.003 | 0.29 ± 0.09 |
| C16:1n-7 | 4.53 ± 0.15 | 4.39 ± 0.08 |
| C17:1n-7 | 0.24 ± 0.01* | 0.18 ± 0.01 |
| C18:1n-9c | 17.20 ± 0.76 | 17.68 ± 0.77 |
| ΣMUFA | 22.21 ± 0.72 | 22.55 ± 0.66 |
| C18:2n-6c | 22.44 ± 0.03* | 24.05 ± 0.56 |
| C18:3n-6 | 0.84 ± 0.01* | 1.23 ± 0.13 |
| C20:2n-6 | 0.66 ± 0.07** | 0.79 ± 0.03 |
| C20:3n-6 | 1.05 ± 0.07 | 1.15 ± 0.16 |
| Σn-6PUFA | 25.00 ± 0.15* | 27.22 ± 0.61 |
| C18–3n-3 | 2.41 ± 0.12 | 2.53 ± 0.07 |
| C20:3n-3 | 0.43 ± 0.02** | 0.33 ± 0.01 |
| C22:5n-3 | 1.37 ± 0.10 | 1.42 ± 0.14 |
| C20:5n-3(EPA) | 4.05 ± 0.72 | 3.57 ± 0.3 |
| C22:6n-3(DHA) | 5.80 ± 0.66 | 5.45 ± 0.46 |
| Σn-3PUFA | 14.70 ± 0.47* | 12.97 ± 0.61 |
The composition and content of total fatty acids and free fatty acids of grass carp under different modes of aquaculture (%, n = 3, dry matter).
*denotes a significant difference (P < 0.05), ** indicates a highly significant difference (P < 0.01). SFA indicates the saturated fatty acids. MUFA indicates the monounsaturated fatty acids. PUFA indicates the polyunsaturated fatty acids. Σn-3 indicates the total content of ω-3 fatty acids. Σn-6 represents the total content of ω-6 fatty acids.
4 Discussion
4.1 Effects of culture modes on the growth of cultured organisms
The results of this study indicate that under the same stocking density, the FCR and SGR of the grouper in the RAS were both higher than those in the SPS, showing superior growth performance (Table 1). Additionally, the output in the RAS was higher than that in the SPS within the same culture period. This aligns with the findings of Zhang et al. (2011) who reported that the growth performance of yellow catfish (Pelteobagrus fulvidraco) in a RAS was superior to that of the control group. As a result, the high production performance of industrialized recirculating aquaculture as an eco-friendly aquaculture mode has attracted significant attention. By comparing the growth performance of yellow catfish in the RAS and open pond aquaculture system, Paolo Melotti (2014) found that under significantly higher stocking densities in the RAS, the final body length, weight, survival rate, and SGR of the yellow catfish were all higher than those in pond aquaculture. This suggested that from the perspective of increasing production, the performance of the RAS was superior to extensive open pond aquaculture. Fish as poikilothermic vertebrates were susceptible to environmental factors such as water flow, depth, temperature, and water quality (Oca and Masalo, 2013). Compared to traditional pond aquaculture, the RAS had stronger water flow, more stable temperature control, and could maintain key water quality factors (e.g. NH4+-N, NO2–N) at lower levels, providing a favorable growth environment for aquaculture organisms, thereby exerting a positive influence on their growth.
4.2 Effects of culture modes on the health of cultured organisms
Vibriosis is one of the most severe bacterial diseases in marine aquaculture. Wei et al. (2020) found that vibriosis accounted for 66.7% of the diseases in grouper, with a mortality rate of 50%. In the process of aquaculture, high abundance of Vibrio or environmental stimuli could lead to outbreaks of vibriosis in cultured organisms (Stalin and Srinivasan, 2017). The results of this experiment showed that the concentration of Vibrio in the intestines of grouper in the RAS was significantly lower than that in the SPS, indicating better safety performance. This matched the findings reported by (Middlemiss et al., 2015) demonstrating that ultraviolet light devices could reduce Vibrio levels and enhance the safety of aquaculture systems.
Intestinal microbiota were found to play a crucial role in regulating the nutrition, immunity, and pathogen antagonism of fish, and its composition and abundance were important indicators of the health of cultured organisms (Banerjee and Ray, 2017). The experimental results (Figure 4) indicated that there was no significant difference in the microbial diversity of grouper intestines between the SPS and RAS groups (P > 0.05), but the diversity in the RAS group was slightly lower than that in the SPS group. This might be attributed to the UV sterilization device in the RAS system, which sterilized the culture water during the circulation process. This could result in fewer environmental bacteria in the RAS group, thus affecting the intestinal microbiota of grouper. The higher diversity of microbiota indicated a greater stability, but it might also harbor potential pathogens, which was closely related to dominant microbial communities (Vine et al., 2004). Analysis of the intestinal microbiota composition of the grouper implied that the dominant phyla in the intestines of grouper in both aquaculture modes are Firmicutes, Proteobacteria, Bacteroidetes, and Actinobacteria. This finding was consistent with the composition of the intestinal microbiota in healthy fish reported by Wang et al. (2018). The aquaculture mode did not change the microbial species in the fish intestines, but it exerted a certain influence on their abundance. In the RAS, the relative abundance of Firmicutes and Bacteroidetes was significantly higher than that in the SPS, while the relative abundance of Proteobacteria was lower than that in the SPS, and the relative abundance of Actinobacteria was significantly lower than that in the SPS. Firmicutes could produce various enzymes to promote the decomposition and absorption of nutrients. Zhu et al. (2021) discovered that an increase in the abundance of Firmicutes in the intestines under the same dietary conditions was conducive to yellow catfish obtaining more energy from food. Bacteroidetes could participate in carbohydrate decomposition and protein metabolism, and its increased abundance was beneficial for enhancing mucosal barrier function and body immune response (Hiippala et al., 2018). Desulfobacterota was a rare aquatic microbial group in the fish intestines, and the relatively high abundance of this group in the experiment was speculated to be related to the aquaculture water environment.
In the aquaculture industry, fish diseases spread rapidly, are highly infectious, and are difficult to treat. Once a disease occurs, it can affect the quality of aquatic products and the stability of aquaculture systems, causing significant economic losses (Lafferty et al., 2015). Accumulation of sediment and aging of water quality in pond aquaculture systems were potential factors for disease outbreaks, and pond systems, being open aquaculture systems, were also susceptible to disease introduction through water exchange with the external environment (Wanja et al., 2020). RASs were independent and closed systems equipped with sediment filtration, UV or ozone sterilization, and the microbiota in the biofilter could regulate water quality and produce antagonistic effects against pathogens such as Vibrio within the system, which enhanced the overall safety (Holan, 2020; Schinke et al., 2017).
4.3 Effects of culture modes on off-flavor compounds in fish
Off-flavor compounds could significantly affect the flavor and commercial value of aquatic products. Geosmin and 2-methylisoborneol were commonly encountered off-flavor compounds in aquaculture. They were primarily produced by cyanobacteria, various species of Streptomyces and fungi (Abd El-Hack et al., 2022). When absorbed through the gills, skin, and intestines, these substances could cause fish to develop off-flavors, thus reducing the quality and economic value of the fish (Nerenberg et al., 2000).
While reports on off-flavor compounds in aquaculture primarily focused on freshwater systems, some studies found that Actinomycetes in marine water systems could also produce off-flavor compounds, which could accumulate in RASs (Azaria and Van Rijn, 2018). In this study, geosmin and 2-methylisoborneol were not detected in the tissues of fish from both the SPS and the RAS. This absence might be associated with the species of cultured organisms, as there was limited information regarding the presence of off-flavor compounds in the grouper. However, the relative abundance of Actinomycetes in the RAS was significantly lower than that in the SPS (P < 0.01). This was due to the fact that the ultraviolet germicidal system in the RAS could eradicate microorganisms in the aquaculture systems (Semenov and Semenova, 2022). Furthermore, the advanced oxidation process (Bunlipatanon and U-taynapun, 2017; Zorzi et al., 2023) and biological treatment in the recirculating water system could degrade geosmin and 2-methylisoborneol (Lindholm-Lehto and Vielma, 2019). This suggested that, for marine aquaculture systems, the likelihood of off-flavor compounds accumulating was higher in pond systems than in the RAS.
4.4 Effects of culture modes on muscle nutrient composition
The muscle is the main nutritional part of fish, and the composition and content of moisture, ash, crude protein, and crude lipid are the basic indicators for assessing the nutritional value of muscle (Ahmed et al., 2022). The experimental results (Table 2) showed that there were no significant differences in the moisture, ash, crude protein, and crude lipid content between the RAS and SPS groups. This finding indicated that, compared to the pond aquaculture mode, the recirculating aquaculture mode did not reduce the nutritional value of the grouper.
As shown in Table 3, 18 amino acids were detected in the muscles of both grouper in the experiment, which was consistent with the amino acid composition reported by Feng et al. (2020) for grouper muscle-tissue samples. Although the types of amino acids detected in the two aquaculture modes were the same, their contents differed: the RAS group exhibited higher total amino acid content, essential amino acid content, NEAA content, and DDA content compared to the SPS group, with the NEAA and umami amino acid content being significantly higher than those in the SPS group. This finding indicated that the aquaculture mode did not affect the types of amino acids in the muscle of the grouper, but it did affect the amino acid composition.
The freshness and deliciousness of fish protein depended on the composition and level of DAAs, including aspartic acid, glutamic acid, glycine, and alanine. In this experiment, the DAAs in the RAS group were significantly higher than those in the SPS group, indicating that the umami flavor of the grouper in the RAS was superior to that of the SPS grouper. The accumulation of DAAs was significantly related to the mode of aquaculture.
From the perspective of AAS and CS scores, both aquaculture modes showed lysine and methionine scores higher than 1 (Table 4), indicating that consumption of grouper could compensate for the lack of lysine and methionine in the human body and promote normal growth and development (Tomé and Bos, 2007).
Fatty acids are mainly divided into SFAs and UFAs. The SFAs are important sources of energy, and are consumed first (Trushenski et al., 2013). UFAs are a unique bioactive substance that exerts various effects on the human body, including regulating blood lipids, reducing cholesterol, suppressing inflammation, and preventing cardiovascular diseases. Among them, the ω-6 series, ω-3 series, EPA, and DHA were important indicators used when evaluating the nutritional value of fatty acids, which can improve human health and nutritional status (Alagawany et al., 2022). In the present study, the total amounts of SFAs and UFAs in the RAS group were higher than that in the SPS group, and the ω-6 series in PFAs was significantly higher than that in the SPS group (Table 5). This was related to the different water-flow environments. In this experiment, the RAS had flowing water with a flow rate of 200 L/h, and the grouper remained active in the system, while the SPS group was in relatively quiescent water. Previous research showed that the activity of fish increased the overall energy consumption, requiring more feed to be converted into body-energy substances for supplementation, thereby altering the proportion of fatty acids (Palstra and Planas, 2011). This finding was consistent with the findings reported by Jia et al. (2022). Additionally, the water quality conditions in the RAS were superior to those in the SPS, which had a positive effect on the accumulation of UFAs (Copeman et al., 2013). It is worth mentioning that the contents of linoleic acid and linolenic acid, as essential fatty acids that the human body could not synthesize, were higher in the RAS group than in the SPS group.
In conclusion, based on the experimental data, the nutritional value of the grouper muscle produced by the RAS was superior to that of the SPS.
4.5 Economic analysis of RASs versus traditional pond systems
Compared to conventional pond aquaculture, the establishment and operation expenses of RASs were notably elevated. The RAS necessitated meticulous precision in system design and control parameters due to its incorporation of temperature regulation and water circulation functionalities, which could in turn escalate expenditure on electricity. Consequently, RASs predominantly served for the cultivation of high-value and economically consequential species, frequently alongside intensified stocking densities, thereby typically yielding substantial returns. In this study, under equivalent initial stocking densities, the FCR and growth rate of the grouper in the RASs were significantly higher than those in SPSs, In comparison to the findings of De et al. (2016) regarding the FCR of hybrid groupers in pond farming, our study observed higher FCR values. Huang et al. (2023) reported FCR values ranging from 6 to 17 in grouper cage farming. Therefore, RASs facilitated enhanced feed utilization efficiency, resulting in cost savings in production. Moreover, the pathogen concentration in RASs was lower than in SPSs, indicating superior disease management over traditional pond farming. Hybrid groupers were highly favored in aquaculture due to their rapid growth and strong disease resistance (Natnan et al., 2023). With diminishing wild fish resources, there was considerable potential for the aquaculture of hybrid groupers. From a long-term perspective, although RASs involved a higher initial operational investment, its ability to achieve higher FCR and SGR, and reduce pathogen levels could make it suitable for implementation in hybrid grouper farming.
This study focused on the influences of macroscopic aquaculture patterns on the growth and nutritional quality of hybrid groupers. Subsequent experiments could further explore differences in aquaculture patterns, such as the effects of various water-quality parameters, temperature, pH, and their influences on cultured organisms.
5 Conclusion
In this study, the hybrid grouper (Pinephelus fuscoguttatus ♀ × Epinephelus lanceolatus ♂) demonstrates superior growth performance, muscle nutrition, and taste in a RAS. Additionally, the groupers in the RAS demonstrated lower pathogen levels, and a better flavor and nutritional composition. Therefore, as a novel aquaculture system, the RAS not only possesses high productivity but also offers enhanced safety and reliability. This mode of aquaculture presents advantages in terms of flavor and nutritional composition, and thus, warrants further promotion.
Statements
Data availability statement
The data presented in the study are deposited in the NCBI repository, accession number PRJNA1116558.
Ethics statement
The animal study was approved by Institutional Animal Ethics Committee of Yellow Sea Fisheries Research Institute. The study was conducted in accordance with the local legislation and institutional requirements.
Author contributions
YQ: Writing – original draft, Writing – review & editing, Conceptualization, Data curation, Formal analysis, Funding acquisition, Investigation, Methodology, Project administration, Resources, Software, Supervision, Validation, Visualization. ZY: Project administration, Writing – review & editing. XF: Data curation, Writing – review & editing. HH: Conceptualization, Writing – review & editing. HC: Software, Writing – review & editing. ZC: Conceptualization, Writing – review & editing. KQ: Supervision, Writing – review & editing. HL: Writing – review & editing.
Funding
The author(s) declare that financial support was received for the research, authorship, and/or publication of this article. The research described herein is supported by the National Key R&D Program of China, Ministry of Science and Technology of People’s Republic of China (Grant Nos 2022YFD2001704 and 2023YFD2400400) and a Basic Scientific Research Project of Chinese Academy of Fishery Sciences (2023TD53).
Conflict of interest
The authors declare that the research was conducted in the absence of any commercial or financial relationships that could be construed as a potential conflict of interest.
Publisher’s note
All claims expressed in this article are solely those of the authors and do not necessarily represent those of their affiliated organizations, or those of the publisher, the editors and the reviewers. Any product that may be evaluated in this article, or claim that may be made by its manufacturer, is not guaranteed or endorsed by the publisher.
References
1
Abd El-Hack M. E. El-Saadony M. T. Elbestawy A. R. Ellakany H. F. Abaza S. S. Geneedy A. M. et al . (2022). Undesirable odour substances (geosmin and 2-methylisoborneol) in water environment: Sources, impacts and removal strategies. Mar. pollut. Bull.178, 113579. doi: 10.1016/j.marpolbul.2022.113579
2
Ahmed I. Jan K. Fatma S. Dawood M. A. O. (2022). Muscle proximate composition of various food fish species and their nutritional significance: A review. J. Anim. Physiol. Anim. Nutr.106, 690–719. doi: 10.1111/jpn.13711
3
Alagawany M. Elnesr S. S. Farag M. R. El-Sabrout K. Alqaisi O. Dawood M. A. O. et al . (2022). Nutritional significance and health benefits of omega-3, -6 and -9 fatty acids in animals. Anim. Biotechnol.33, 1678–1690. doi: 10.1080/10495398.2020.1869562
4
Azaria S. Van Rijn J. (2018). Off-flavor compounds in recirculating aquaculture systems: Production and removal processes. Aquacultural Eng.83, 57–64. doi: 10.1016/j.aquaeng.2018.09.004
5
Banerjee G. Ray A. K. (2017). Bacterial symbiosis in the fish gut and its role in health and metabolism. Symbiosis72, 1–11. doi: 10.1007/s13199-016-0441-8
6
Bunlipatanon P. U-taynapun K. (2017). Growth performance and disease resistance against Vibrio vulnificus infection of novel hybrid grouper (Epinephelus lanceolatus × Epinephelus fuscoguttatus). Aquaculture Res.48, 1711–1723. doi: 10.1111/are.13008
7
Cherian T. Ragavendran C. Vijayan S. Kurien S. Peijnenburg W. J. G. M. (2023). A review on the fate, human health and environmental impacts, as well as regulation of antibiotics used in aquaculture. Environ. Adv.13, 100411. doi: 10.1016/j.envadv.2023.100411
8
Copeman L. A. Laurel B. J. Parrish C. C. (2013). Effect of temperature and tissue type on fatty acid signatures of two species of North Pacific juvenile gadids: A laboratory feeding study. J. Exp. Mar. Biol. Ecol.448, 188–196. doi: 10.1016/j.jembe.2013.07.008
9
De M. Ghaffar M. A. Bakar Y. Das S. K. (2016). Effect of temperature and diet on growth and gastric emptying time of the hybrid, Epinephelus fuscoguttatus ♀× E. lanceolatus ♂. Aquaculture Rep.4, 118–124. doi: 10.1016/j.aqrep.2016.08.002
10
Edwards P. Little D. C. Yakupitiyage A. (1997). A comparison of traditional and modified inland artisanal aquaculture systems. Aquaculture Res. 28 (10), 777–788. doi: 10.1111/j.1365-2109.1997.tb01002.x
11
FAO . (2022) The State of World Fisheries and Aquaculture 2022. Towards Blue Transformation. Rome, FAO. doi: 10.4060/cc0461en
12
FAO/WHO . (1973). Energy and protein requirements. Report of a Joint FAO/WHO Ad. Expert Committee.
13
Feng H. Yi K. Qian X. Niu X. Sun Y. Ye J. (2020). Growth and metabolic responses of juvenile grouper (Epinephelus coioides) to dietary methionine/cystine ratio at constant sulfur amino acid levels. Aquaculture518, 734869. doi: 10.1016/j.aquaculture.2019.734869
14
Fisheries Bureau of the Ministry of Agriculture and Rural Affairs . China Fishery Statistical Year Book 2023. Beijing, China Agriculture Press. (In Chinese)
15
Hiippala K. Jouhten H. Ronkainen A. Hartikainen A. Kainulainen V. Jalanka J. et al . (2018). The potential of gut commensals in reinforcing intestinal barrier function and alleviating inflammation. Nutrients10 (8), 988. doi: 10.3390/nu10080988
16
Holan A. B. (2020). 9—Health management in recirculating aquaculture systems. Academic Press2020, 281–318. doi: 10.1016/B978-0-12-813359-0.00009-9
17
Hu B. Zhou J. Qiu H. Lai X. Li J. Wu D. Hong Y. (2021). Comparison of nutritional quality and volatile flavor compounds among bighead carp from three aquaculture systems. Saudi Journal of Biological Sciences28(8), 4291–4299.
18
Huang P.-L. Afero F. Chang Y. Chen B.-Y. Lan H.-Y. Hou Y.-L. et al . (2023). The Bioeconomic Analysis of Hybrid Giant Grouper (Epinephelus fuscoguttatus × Epinephelus lanceolatus) and Green Grouper (Epinephelus malabaricus): A Case Study in Taiwan. Fishes8, 610. doi: 10.3390/fishes8120610
19
Jia S. Wang L. Zhang J. Zhang L. Ma F. Huang M. et al . (2022). Comparative study on the morphological characteristics and nutritional quality of largemouth bass (Micropterus salmoides) cultured in an aquaculture system using land-based container with recycling water and a traditional pond system. Aquaculture549, 737721. doi: 10.1016/j.aquaculture.2021.737721
20
Lafferty K. D. Harvell C. D. Conrad J. M. Friedman C. S. Kent M. L. Kuris A. M. et al . (2015). Infectious diseases affect marine fisheries and aquaculture economics. Annu. Rev. Mar. Sci.7, 471–496. doi: 10.1146/annurev-marine-010814-015646
21
Li H. Cui Z. Cui H. Bai Y. Yin Z. Qu K. (2023a). A review of influencing factors on a recirculating aquaculture system: Environmental conditions, feeding strategies, and disinfection methods. J. World Aquaculture Soc.54, 566–602. doi: 10.1111/jwas.12976
22
Li H. Cui Z. Cui H. Bai Y. Yin Z. Qu K. (2023b). Hazardous substances and their removal in recirculating aquaculture systems: A review. Aquaculture569, 739399. doi: 10.1016/j.aquaculture.2023.739399
23
Lindholm-Lehto P. C. Vielma J. (2019). Controlling of geosmin and 2-methylisoborneol induced off-flavours in recirculating aquaculture system farmed fish—A review. Aquaculture Res.50, 9–28. doi: 10.1111/are.13881
24
Ma F. Wang L. Huang J. Chen Y. Zhang L. Zhang M. et al . (2023). Comparative study on nutritional quality and serum biochemical indices of common carp (Cyprinus carpio) aged 11 to 13 months aged cultured in traditional ponds and land-based container aquaculture systems. Food Res. Int.169, 112869. doi: 10.1016/j.foodres.2023.112869
25
Middlemiss K. L. Daniels C. L. Urbina M. A. Wilson R. W. (2015). Combined effects of UV irradiation, ozonation, and the probiotic Bacillus spp. On growth, survival, and general fitness in European lobster (Homarus gammarus). Aquaculture444, 99–107. doi: 10.1016/j.aquaculture.2015.03.028
26
Mougin J. Roquigny R. Flahaut C. Bonnin-Jusserand M. Grard T. Le Bris C. (2021). Abundance and spatial patterns over time of Vibrionaceae and Vibrio harveyi in water and biofilm from a seabass aquaculture facility. Aquaculture542, 736862. doi: 10.1016/j.aquaculture.2021.736862
27
Muhala V. Chicombo T. F. Macate I. E. Guimarães-Costa A. Gundana H. Malichocho C. et al . (2021). Climate change in fisheries and aquaculture: analysis of the impact caused by idai and kenneth cyclones in Mozambique. Front. Sustain. Food Syst.5. doi: 10.3389/fsufs.2021.714187
28
Natnan M. E. Low C.-F. Chong C.-M. Bunawan H. Baharum S. N. (2023). Oleic acid as potential immunostimulant in metabolism pathways of hybrid grouper fingerlings (Epinephelus fuscoguttatus × Epinephelus lanceolatus) infected with Vibrio vulnificus. Sci. Rep.13, 12830. doi: 10.1038/s41598–023-40096–7
29
Nerenberg R. Rittmann B. E. Soucie W. J. (2000). Ozone/biofiltration for removing MIB AND GEOSMIN. J. AWWA92, 85–95. doi: 10.1002/j.1551-8833.2000.tb09073.x
30
Oca J. Masalo I. (2013). Flow pattern in aquaculture circular tanks: Influence of flow rate, water depth, and water inlet & outlet features. Aquacultural Eng.52, 65–72. doi: 10.1016/j.aquaeng.2012.09.002
31
Palstra A. P. Planas J. V. (2011). Fish under exercise. Fish Physiol. Biochem.37, 259–272. doi: 10.1007/s10695-011-9505-0
32
Paolo Melotti L. S. (2014). Comparison of growth performance of ‘Common catfish ameiurus melas, rafinesque1820’, reared in pond and in recirculating aquaculture system. J. Aquaculture Res. Dev.05. doi: 10.4172/2155-9546
33
Rimmer M. A. Glamuzina B. (2019). A review of grouper (Family Serranidae: Subfamily Epinephelinae) aquaculture from a sustainability science perspective. Rev. Aquaculture11, 58–87. doi: 10.1111/raq.12226
34
Schinke C. Martins T. Queiroz S. C. N. Melo I. S. Reyes F. G. R. (2017). Antibacterial compounds from marine bacteria 2010–2015. J. Natural Products80, 1215–1228. doi: 10.1021/acs.jnatprod.6b00235
35
Semenov A. Semenova K. (2022). Ultraviolet disinfection of water in recirculating aquaculture system: A case study at sturgeon caviar fish farm. Acta Agriculturae Slovenica118. doi: 10.14720/10.14720/aas.2022.118.3
36
Stalin N. Srinivasan P. (2017). Efficacy of potential phage cocktails against Vibrio harveyi and closely related Vibrio species isolated from shrimp aquaculture environment in the south east coast of India. Veterinary Microbiol.207, 83–96. doi: 10.1016/j.vetmic.2017.06.006
37
Tomé D. Bos C. (2007). Lysine requirement through the human life cycle. J. Nutr.137, 1642S–1645S. doi: 10.1093/jn/137.6.1642S
38
Trushenski J. Mulligan B. Jirsa D. Drawbridge M. (2013). Sparing fish oil with soybean oil in feeds for white seabass: effects of inclusion rate and soybean oil composition. North Am. J. Aquaculture75, 305–315. doi: 10.1080/15222055.2012.720650
39
Vine N. G. Leukes W. D. Kaiser H. Daya S. Baxter J. Hecht T. (2004). Competition for attachment of aquaculture candidate probiotic and pathogenic bacteria on fish intestinal mucus. J. Fish Dis.27, 319–326. doi: 10.1111/j.1365-2761.2004.00542.x
40
Wang C. Sun G. Li S. Li X. Liu Y. (2018). Intestinal microbiota of healthy and unhealthy Atlantic salmon Salmo salar L. in a recirculating aquaculture system. J. Oceanology Limnology36, 414–426. doi: 10.1007/s00343-017-6203-5
41
Wang X. Xie Q. Zhang L. Qu B. Liu Y. Xiao L. Wu Z. (2023). A Rapid Detection Method for Off-flavor Compounds in Fish Based on Dispersed Solid Phase Extraction Technology. Food Research and Development44(09), 171–177. (In Chinese)
42
Wanja D. W. Mbuthia P. G. Waruiru R. M. Mwadime J. M. Bebora L. C. Nyaga P. N. et al . (2020). Fish husbandry practices and water quality in central Kenya: potential risk factors for fish mortality and infectious diseases. Veterinary Med. Int. 2020. doi: 10.1155/2020/6839354
43
Wei G. Cai S. Wu Y. Ma S. Huang Y. (2020). Immune effect of Vibrio harveyi formalin-killed cells vaccine combined with chitosan oligosaccharide and astragalus polysaccharides in ♀ Epinephelus fuscoguttatus × ♂ Epinephelus lanceolatus. Fish Shellfish Immunol.98, 186–192. doi: 10.1016/j.fsi.2020.01.015
44
Yue K. Shen Y. (2022). An overview of disruptive technologies for aquaculture. Aquaculture Fisheries7, 111–120. doi: 10.1016/j.aaf.2021.04.009
45
Zhang S.-Y. Li G. Wu H.-B. Liu X.-G. Yao Y.-H. Tao L. et al . (2011). An integrated recirculating aquaculture system for land-based fish farming: The effects on water quality and fish production. Aquacultural Eng.45, 93–102. doi: 10.1016/j.aquaeng.2011.08.001
46
Zhang Y. Lu R. Qin C. Nie G. (2020). Precision nutritional regulation and aquaculture. Aquaculture Rep.18, 100496. doi: 10.1016/j.aqrep.2020.100496
47
Zhu H. Qiang J. Xu G. Tao Y. Bao J. Xu P. (2021). Microbial community structure of hybrid yellow catfish in rice-fish co-culture system in the Hani terrace. Acta Hydrobiologica Sin.45, 1232–1242. doi: 10.7541/2021.2020.179
48
Zorzi V. Bertini A. Robertson A. Berardinelli A. Palmisano L. Parrino F. (2023). The application of advanced oxidation processes including photocatalysis-based ones for the off-flavours removal (GSM and MIB) in recirculating aquaculture systems. Mol. Catalysis551, 113616. doi: 10.1016/j.mcat.2023.113616
Summary
Keywords
hybrid grouper, recirculating aquaculture system, pond system, intestinal flora, nutritional component
Citation
Qu Y, Yin Z, Fan X, Hu H, Cui H, Cui Z, Qu K and Li H (2024) A comparative analysis of growth and nutritional quality of the hybrid grouper (Epinephelus fuscoguttatus ♀ × Epinephelus lanceolatus ♂) in a simulated pond system and a recirculating aquaculture system. Front. Mar. Sci. 11:1378735. doi: 10.3389/fmars.2024.1378735
Received
30 January 2024
Accepted
21 May 2024
Published
06 June 2024
Volume
11 - 2024
Edited by
Hüseyin Sevgili, Isparta University of Applied Sciences, Türkiye
Reviewed by
Anselmo Miranda-Baeza, State University of Sonora, Mexico
Mohamed Moaaz Refaey, Mansoura University, Egypt
Updates
Copyright
© 2024 Qu, Yin, Fan, Hu, Cui, Cui, Qu and Li.
This is an open-access article distributed under the terms of the Creative Commons Attribution License (CC BY). The use, distribution or reproduction in other forums is permitted, provided the original author(s) and the copyright owner(s) are credited and that the original publication in this journal is cited, in accordance with accepted academic practice. No use, distribution or reproduction is permitted which does not comply with these terms.
*Correspondence: Hao Li, lihao@ysfri.ac.cn
Disclaimer
All claims expressed in this article are solely those of the authors and do not necessarily represent those of their affiliated organizations, or those of the publisher, the editors and the reviewers. Any product that may be evaluated in this article or claim that may be made by its manufacturer is not guaranteed or endorsed by the publisher.